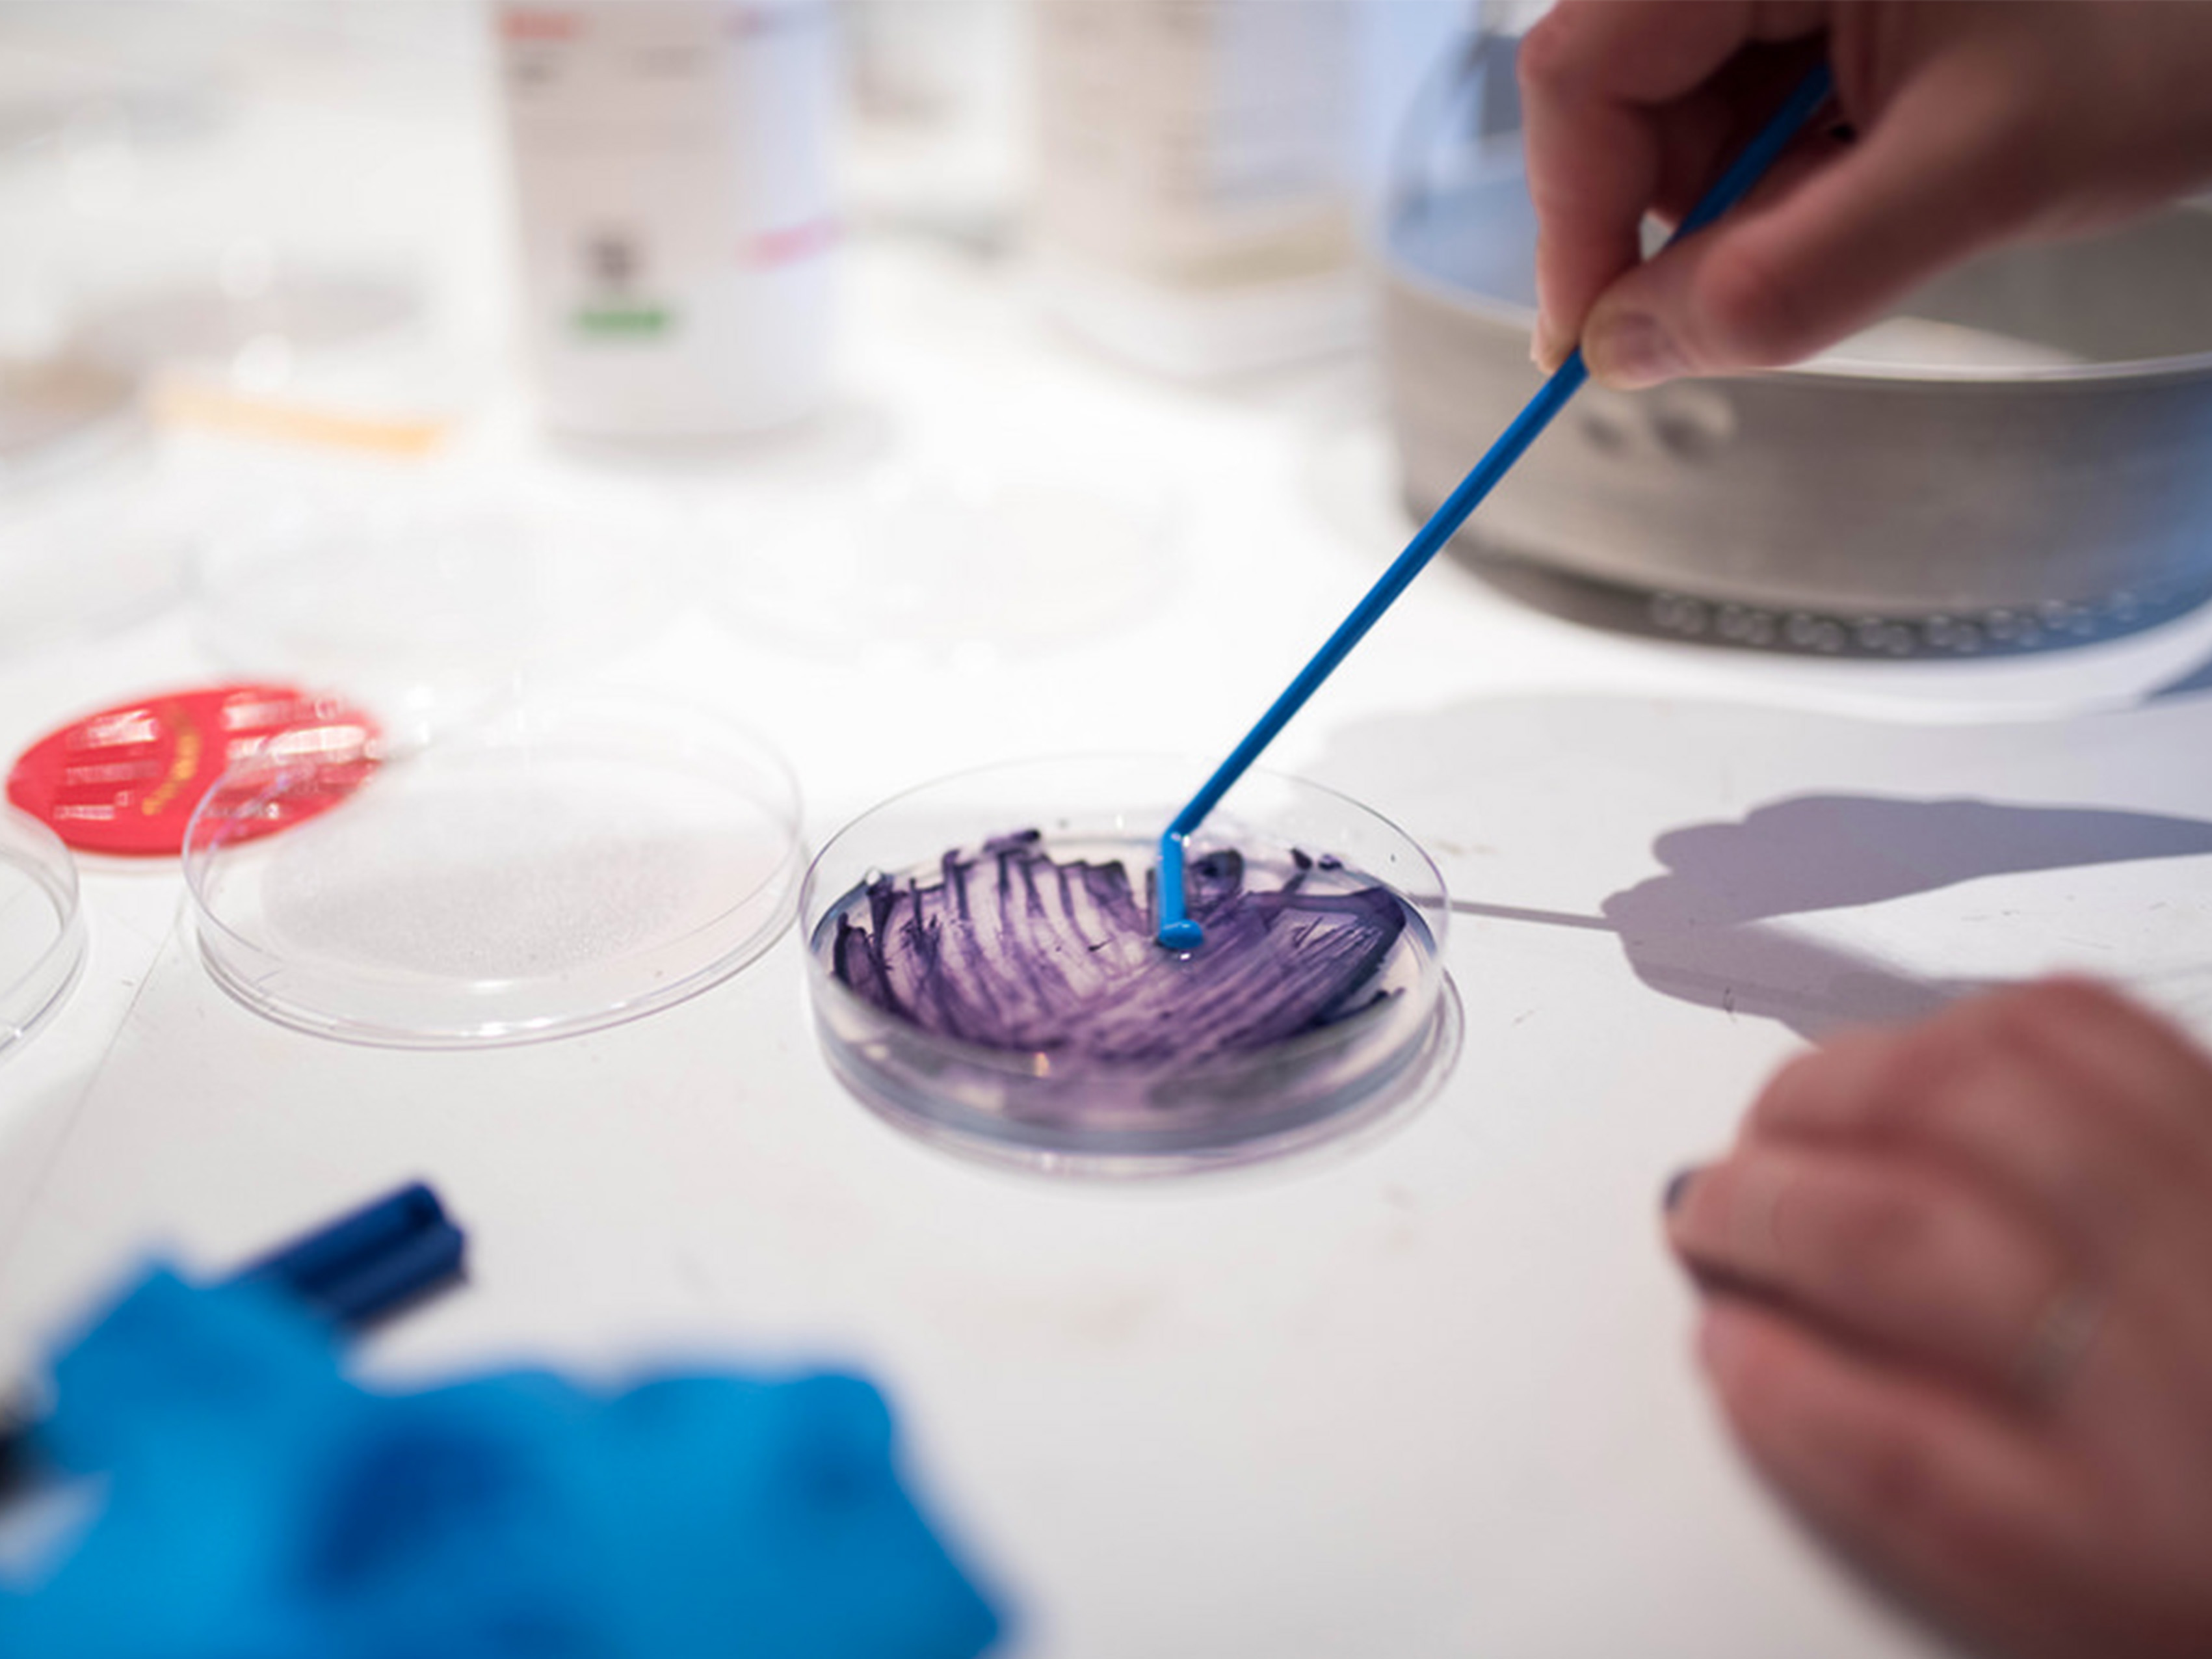

BioShades Workshop, TCBL, Fab Textiles, Mazda Space, Barcelona, March 2018
.
Textile dyeing chemical processes contributes significantly to pollution and results in waste products that find their way into our rivers and oceans. This problem can be addressed through the use of natural dyes, and by educating consumers on how to develop these on their own, using local raw materials. In the future, even the materials themselves will be consumer-produced. This forges a closer relationship between consumers and products, leading to a more sustainability-conscious society. Could dyeing with bacteria be an alternative to chemical dyes? With BioShades we explore the potential of dyeing with bacteria as a less harmful alternative to the environment. BioShades is a project part of TCBL that aims to renew the European Textile & Clothing sector. We explore new ways to design, make, and work together for inventing new business models to open up new markets.
https://www.youtube.com/watch?v=gJvxqujkUvI&feature=youtu.be MASDA SPACE - BIOSHADES WORKSHOP - 15TH OF MARCH 2017 The TCBL event was organized in a distributed way, running in many Labs all over the world at the same time. In Barcelona, 22 participants gathered in Mazda Space and performed a global experiment following a live demonstration lead by the TextileLab Amsterdam. Participating TCBL labs were set up with an inventory that included petri plates, inoculation loops, prepared nutrient broth, sufficient sterilization and safety equipment, and a sample of natural textile like silk. The bacteria used is called Janthinobacterium lividum (violacein) and the medium of growth is agar and LB broth. Textile dyeing with bacteria is part of the Fabricademy classes content.

BioShades Workshop, TCBL, Fab Textiles, Mazda Space, Barcelona, 2018
.
BioShades Workshop, Textile Lab Amsterdam, Waag Society, Amsterdam, 2018
.
After an introduction into the days program and an overview of the previous research conducted, the participants were given instructions to fold or scrunch their silk samples - giving room for designers creativity and versatility of results.The samples were compiled and placed in an autoclave bag for 15 mins of sterilization, enough to kill off any previous microorganisms. Each sample was then placed in a sterile petri plate working within 10 cm of the Bunsen burner were the prepared LB broth was dispensed equally into each plate.Then each fabric was placed in a petri-dish, filled with LB broth medium and inoculated with the bacteria. Following this the plates were placed in the incubator with a temperature of 25ºC and left to colonize the fabric for 4-5 days. The unfolded results are as shown.

Bacteria dyeing experiments, BioShades Workshop, Fabricademy, Fab Textiles, Mazda Space, Barcelona, 2018
.



Bacteria dyeing results, BioShades Workshop, Fabricademy, Fab Textiles, Mazda Space, Barcelona, 2018
.
Check the interview made from Vice Creators on Textile Bacteria Dyeing